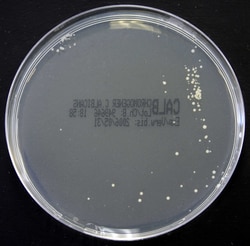
Thermo Scientific Oxoid Chromogenic Candida albicans Agar | Buy Online | Thermo Scientific&trade; | Fisher Scientific
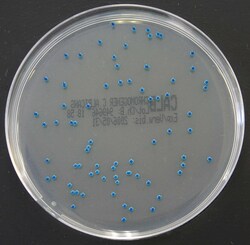
Thermo Scientific Oxoid Chromogenic Candida albicans Agar | Buy Online | Thermo Scientific&trade; | Fisher Scientific

Learn More
Thermo Scientific™ Oxoid™ Chromogenic Candida albicans Agar
Beschreibung
Presumptively identify Candida albicans from clinical specimens with ready-to-use Thermo Scientific™ Oxoid™ Chromogenic Candida albicans Agar.
Chromogenic C. albicans Agar enables the differentiation of Candida albicans as blue colonies, whereas other Candida species grow as colorless colonies. The devices are for professional use only, are not automated, and are not for companion diagnostics.
Use Chromogenic C. albicans Agar for isolation and presumptive identification of Candida albicans from clinical specimens.
- Easy isolation and presumptive identification of Candida albicans
- Candida albicans differentiation as blue colonies
- Ready-to-use convenience of prepared media
Chromogenic C. albicans Agar is a selective chromogenic medium for the isolation of Candida spp. and presumptive identification of C. albicans. Differentiation of C. albicans is achieved by the addition of chromogenic substrate to detect the activity of enzyme β-Glucosaminidase.

Spezifikation
Spezifikation
| Inhalt und Lagerung | 2° to 12°C |
| Beschreibung | Chromogenic Candida albicans Agar |
| Zur Verwendung mit (Anwendung) | Clinical samples |
| Menge | 10 plates |
Bitte geben Sie uns Ihr Feedback zu den Produktinhalten, indem Sie das folgende Formular ausfüllen.